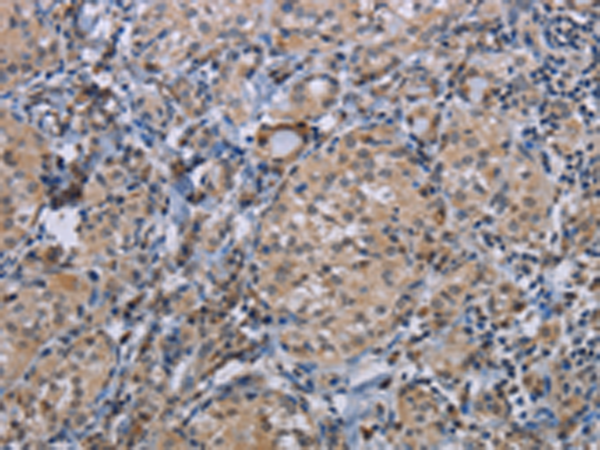

中文名稱:兔抗CDC16多克隆抗體
英文名稱: Anti-CDC16 rabbit polyclonal antibody
別 名: APC6; CUT9; ANAPC6
相關(guān)類別: 一抗
儲 存: 冷凍(-20℃)
宿 主: Rabbit
抗 原: CDC16
標(biāo) 記 物: Unconjugate
克隆類型: rabbit polyclonal
技術(shù)規(guī)格
|
Background: |
This gene encodes a component protein of the APC complex, which is composed of eight proteins and functions as a protein ubiquitin ligase. The APC complex is a cyclin degradation system that governs exit from mitosis. Each component protein of the APC complex is highly conserved among eukaryotic organisms. This protein and two other APC complex proteins, CDC23 and CDC27, contain a tetratricopeptide repeat (TPR), a protein domain that may be involved in protein-protein interaction. |
|
Applications: |
ELISA, WB, IHC |
|
Name of antibody: |
CDC16 |
|
Immunogen: |
Synthetic peptide of human CDC16 |
|
Full name: |
cell division cycle 16 |
|
Synonyms: |
APC6; CUT9; ANAPC6 |
|
SwissProt: |
Q13042 |
|
ELISA Recommended dilution: |
2000-5000 |
|
IHC positive control: |
Human thyroid cancer and Human cervical cancer |
|
IHC Recommend dilution: |
50-200 |
|
WB Predicted band size: |
72 kDa |
|
WB Positive control: |
Human pancreas tissue |
|
WB Recommended dilution: |
500-2000 |

購物車
幫助
021-54845833/15800441009
